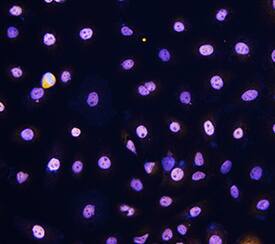
p63/TP73L antibody in SCC-25 Human Cell Line by Immunocytochemistry (ICC).

Human p63/TP73L Biotinylated Antibody
R&D Systems, part of Bio-Techne | Catalog # BAF1916


Conjugate
Catalog #
Key Product Details
Species Reactivity
Validated:
Human
Cited:
Human
Applications
Validated:
Immunohistochemistry, Western Blot, Immunocytochemistry
Cited:
Immunohistochemistry
Label
Biotin
Antibody Source
Polyclonal Goat IgG
Product Specifications
Immunogen
E. coli-derived recombinant human p63/TP73L
Met40-Cys339
Accession # Q9H3D4
Met40-Cys339
Accession # Q9H3D4
Specificity
Detects p63/TP73L in Western blots.
Clonality
Polyclonal
Host
Goat
Isotype
IgG
Scientific Data Images for Human p63/TP73L Biotinylated Antibody
p63/TP73L in Human Prostate.
p63/TP73L was detected in immersion fixed paraffin-embedded sections of human prostate array using Goat Anti-Human p63/TP73L Biotinylated Antigen Affinity-purified Polyclonal Antibody (Catalog # BAF1916) at 15 µg/mL overnight at 4 °C. Tissue was stained using the Anti-Goat HRP-DAB Cell & Tissue Staining Kit (brown; Catalog # CTS008) and counterstained with hematoxylin (blue). Lower panel shows a lack of labeling if primary antibodies are omitted and tissue is stained only with secondary antibody followed by incubation with detection reagents. View our protocol for Chromogenic IHC Staining of Paraffin-embedded Tissue Sections.p63/TP73L in SCC-25 Human Cell Line.
p63/TP73L was detected in immersion fixed SCC-25 human tongue carcinoma cell line using Goat Anti-Human p63/TP73L Biotinylated Antigen Affinity-purified Polyclonal Antibody (Catalog # BAF1916) at 10 µg/mL for 3 hours at room temperature. Cells were stained using the NorthernLights™ 557-conjugated Streptavidin (yellow; Catalog # NL999) and counterstained with DAPI (blue). Specific staining was localized to nuclei. View our protocol for Fluorescent ICC Staining of Cells on Coverslips.Applications for Human p63/TP73L Biotinylated Antibody
Application
Recommended Usage
Immunocytochemistry
5-15 µg/mL
Sample: Immersion fixed SCC-25 human tongue carcinoma cell line
Sample: Immersion fixed SCC-25 human tongue carcinoma cell line
Immunohistochemistry
5-15 µg/mL
Sample: Immersion fixed paraffin-embedded sections of human prostate array
Sample: Immersion fixed paraffin-embedded sections of human prostate array
Western Blot
0.1 µg/mL
Sample: Recombinant Human p63/TP73L
Sample: Recombinant Human p63/TP73L
Formulation, Preparation, and Storage
Purification
Antigen Affinity-purified
Reconstitution
Reconstitute at 0.2 mg/mL in sterile PBS.
Formulation
Lyophilized from a 0.2 μm filtered solution in PBS with BSA as a carrier protein.
Shipping
The product is shipped at ambient temperature. Upon receipt, store it immediately at the temperature recommended below.
Stability & Storage
Use a manual defrost freezer and avoid repeated freeze-thaw cycles.
- 12 months from date of receipt, -20 to -70 °C as supplied.
- 1 month, 2 to 8 °C under sterile conditions after reconstitution.
- 6 months, -20 to -70 °C under sterile conditions after reconstitution.
Background: p63/TP73L
Tumor Protein 63 (p63), also named TP73L, TP63, p51, p40 or KET, is a p53 homolog. It is one of several proteins that are produced from a single gene using two promoters and alternative splicing of the primary RNA transcript. p63 is highly expressed in embryonic ectoderm and in the nuclei of basal regenerative cells of many epithelial tissues in the adult. p63 is suggested to play a role in development, epithelial cell maintenance and tumorigenesis (1‑3).
References
- Harms, K. et al. (2004), Cell Mol. Life Sci. 61(7):822.
- Koster, M.I. and D.R. Roop, J. Dermatol. Sci. 34(1):3.
- Benard, J. et al. (2003) Hum. Mutat. 21(3):182.
Long Name
Tumor Protein 63
Alternate Names
EEC3, KET, OFC8, p40, p51, p73L, SHFM4, TP63, TP73L
Entrez Gene IDs
8626 (Human)
Gene Symbol
TP63
UniProt
Additional p63/TP73L Products
Product Documents for Human p63/TP73L Biotinylated Antibody
Product Specific Notices for Human p63/TP73L Biotinylated Antibody
For research use only
Loading...
Loading...
Loading...
Loading...
Loading...